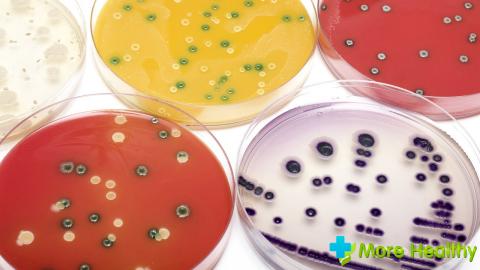

Вопрос о том, чем опасен стафилококк, вызывает интерес у многих людей. В царстве микробов обитают различные по своим свойствам бактерии. Самые сильные и коварные называются патогенными. Они вызывают болезнь всегда (например, чуму). Но есть бактерии, которые способны вызывать болезнь только при определенных условиях и обстоятельствах, то есть условно-патогенные. К ним-то и относится стафилококк — малоподвижная округлая бактерия, размножающаяся аэробным путем.
Особенности стафилококковой инфекции
На бактериальном посеве стафилококки предстают в виде скоплений, напоминающих виноградные гроздья. Отсюда и произошло их название (staphylos в переводе с греческого означает «гроздь»). Сфера их распространения очень велика: они присутствуют практически на каждом человеке, на мебели, одежде, игрушках и других предметах. Но присутствие данного микроба на поверхности кожи и слизистых оболочках человека не всегда предполагает развитие инфекционного процесса.
В медицине существует такое понятие, как здоровое носительство, когда бактерии находятся в равновесии с иммунными силами организма, поэтому не в состоянии подвергнуть его агрессии и вызвать болезнь. В природе большое многообразие стафилококков, среди которых опасными для человека могут быть всего три вида:
- эпидермальный (S.epidemidis);
- сапрофитный (S.saprophyticus);
- золотистый (S.aureus).
Наибольшую угрозу представляет золотистый стафилококк, который получил свое название из-за красивого золотисто-желтого цвета в бактериальном посеве. Данный микроорганизм уникален своей жизнестойкостью. Он прекрасно выдерживает очень высокие и очень низкие температуры, высушивание, для него не представляют опасности такие химические вещества, как этиловый спирт и перекись водорода, а вот к раствору бриллиантовой зелени он, наоборот, очень чувствителен. Поэтому все мелкие ранки на теле необходимо обрабатывать этим защищающим от стафилококка средством.
Данная бактерия мгновенно погибает только при кипячении, а более низкую температуру в 70 градусов может выдерживать в течение часа.
В обычном непастеризованном молоке уже через два часа нахождения вне холодильника начинают размножаться эти микробы, поэтому кипятить его нужно обязательно, особенно, если вы собираетесь давать его детям. Губителен для стафилококка и такой антисептик, как 5%-ный раствор фенола (карболовой кислоты), который используют для дезинфекции помещений.
Основные заболевания, связанные с возбудителем
Заразиться стафилококком можно где угодно и когда угодно. Как уже указывалось выше, его можно обнаружить на мебели, одежде, в комнатной пыли. Почти в каждой квартире присутствует свой «домашний» стафилококк. Вне пределов квартиры можно заразиться воздушно-капельным путем при беседе с носителем стафилококковой инфекции. Но самое раздольное место для стафилококка — это больница. Особенно в родильных домах очень велика вероятность заразиться молодым мамочкам и детям.
Больничный стафилококк намного превосходит «домашнего» по степени устойчивости к антисептикам, поэтому он опаснее. Бактерии могут переходить к ребенку от матери во время грудного вскармливания через молоко и через кровь во время внутриутробного развития плода.
При употреблении несвежих продуктов микроорганизм может вызвать пищевое отравление, которое характеризуется тошнотой, рвотой, почти беспрерывным водянистым стулом. Этот микроорганизм — любитель молочных продуктов, сладостей (тортов, пирожных), консервов и колбасы. Также можно заразиться через хирургические инструменты, при использовании чужого полотенца или мочалки.
Стафилококк защищается от воздействия иммунной системы человека выработкой ферментов, а для атаки на ту же иммунную систему продуцирует токсины эксфолиатин, энтеротоксин и лейкоцидин. Пищевые отравления как раз и вызываются энтеротоксином. Знаменитым французским ученым Луи Пастером еще в позапрошлом веке была доказана взаимосвязь между наличием стафилококка и развитием гнойного процесса. Согласно Международной классификации болезней стафилококк является возбудителем более ста разных заболеваний.
Последствиями воздействия стафилококковой инфекции являются:
- такие заболевания глаз, как конъюнктивит и ячмень;
- многочисленные кожные заболевания (фурункулы, карбункулы, абсцесс, ожогоподобный кожный синдром);
- стафилококковый эндокардит;
- энтероколит;
- ангина;
- отит;
- пневмония;
- кашель;
- гайморит;
- менингит;
- мастопатия и цистит у женщин (в случае цистита возбудителем является сапрофитный стафилококк);
- артрит;
- ринит.
Воздействие стафилококка в 95% случаев вызывает такое серьезное последствие, как остеомиелит. Когда человек находится в реанимации, его организм настолько ослаблен, что не может справиться с микробом. Последствием такого состояния может стать заражение крови (сепсис).
Человек может противодействовать стафилококку, поддерживая свой иммунитет на должном уровне, полноценно питаясь свежими продуктами, соблюдая правила гигиены, обязательно моя руки перед едой, систематически проводя уборку дома.
В наше время, как свидетельствует статистика, стафилококк может существовать на кожной поверхности, в носоглотке, на других слизистых и у только что родившихся детей, и у лиц среднего возраста, и у пожилых людей.
Любому человеку нужно четко осознавать, что стафилококк и стафилококковая инфекция — это две совершенно разные вещи. При симптомах стафилококковой инфекции следует обращаться к врачу.
Описание золотистого стафилококка
Золотой или золотистый стафилококк представляет собой шаровидную бактерию. Такое название микроорганизм получил по внешнему виду: данный вид стафилококков имеет золотистый оттенок в отличие от других бактерий, которые относятся к этому же виду.
Стафилококк является представителем нормальный микрофлоры. При ослаблении иммунитета бактерия вызывает воспалительный процесс в органах и тканях.
Бактерия обычно локализуется на слизистых оболочках, на коже лица и подмышках. Также стафилококк может располагаться на волосистой части головы или в органах желудочно-кишечного тракта.
Золотистый стафилококк может приспосабливаться к различным условиям среды.
Замораживание и воздействие солнечных лучей на стафилококк губительно не действуют. Бактерии погибают при температуре 100 градусов.
Основные пути заражения
Большинство людей являются носителями золотистого стафилококка. Бактерия передается преимущественно воздушно-капельным путем. Также инфицирование возможно при прикосновении с бактерионосителем, а также через употребление зараженной пищи.
Чаще всего золотистый стафилококк обитает на слизистых оболочках, поэтому при тесном контакте с инфицированным человеком повышается риск передачи бактерии другому лицу.
Заражение во многих случаях происходит во время проведения хирургических операций, процедур с установкой катетеров и других устройств. Это возникает при использовании нестерильных медицинских инструментов.
При попадании стафилококка в пищевые продукты, бактерия размножается и выделяет токсины. Заражение может произойти через мясные и молочные продукты, рыбу, мучные изделия.
Чаще всего подвергаются стафилококковой инфекции:
Инфицирование новорожденных чаще всего происходит через родовые пути. При неправильной гигиене стафилококк может проникнуть через трещины в сосках вместе с грудным молоком.
Симптомы золотого стафилококка
Стафилококк, попадая на кожу и слизистые оболочки, выделяет токсины и ферменты, оказывающие губительное воздействие на человека. Обычно признаки стафилококковой инфекции зависят от места локализации, иммунитета, сопутствующих заболеваний и других факторов.
При попадании на кожные покровы бактерия провоцирует развитие угрей, прыщей, фурункулов и т.д. Чаще можно обнаружить на коже пиодермию. Для этого заболевания характерно поражение зоны вокруг устьев волос. В дальнейшем гнойники появляются на шее, ягодицах и бедрах.
Если бактерия поражает волосяную луковицу, то наблюдается уплотнение и покраснение кожи вокруг нее. Во время прикосновения больной ощущает боль. В дальнейшем стафилококк распространяется дальше и захватывает сальные железы. В результате возникает карбункул. При его появлении повышается температура тела и наблюдается общая слабость. Выдавливать самостоятельно гнойник запрещается, так как можно занести инфекцию.
На слизистых оболочках горла или носа золотистый стафилококк приводит к возникновению ангины, синусита, отита и других заболеваний ЛОР-органов.
При стафилококковой ангине повышается температура тела, появляется сильная боль в горле, увеличиваются в размере лимфоузлы. На миндалинах образуется гнойный налет, что также указывает на ангину, причиной которой становится золотистый стафилококк.
У новорожденных бактерия может привести к болезни Риттера. Другое название – синдром ошпаренной кожи. Для этого заболевания характерно шелушение, образование волдырей с дальнейшим отслоением больших пластов кожи. Важно незамедлительно обратиться к врачу, так как бактерия проникнет глубже, что может привести к гнойному расплавлению.
У грудничков стафилококковая инфекция может спровоцировать развитие пневмонии. Это заболевание дети переносят очень тяжело. Для стафилококковой пневмонии характерны отдышка и боль в груди. Во время обследования в тканях легких обнаруживаются очаги воспаления и участки с гнойниками.
Во время проведения операции при заражении золотым стафилококком может возникнуть остеомиелит. Это заболевание характеризуется болью в суставах и мышцах. Особенно сильно болезненность возникает во время движения. Это обусловлено образованием гнойного очага воспаления. Также наблюдается повышение температуры тела, покраснение воспаленного участка.
При поражении органов ЖКТ появляется сухость во рту, тошнота и рвота, жидкий стул, боль в животе.
Важно вовремя начать лечение, так как воспалительный процесс будет распространяться дальше и в результате прорвется свищ с гнойным содержимым.
Диагностика
Для диагностики стафилококка применяют различные материалы: кровь, мокроту, гной, выделения из носа, мочу и др. С этой целью берут мазок из горла, слизистой оболочки носа или других поверхностей.
Выделяют 2 метода диагностики золотого стафилококка: микроскопический и культуральный.
Микроскопическое исследование позволяет обнаружить патогенные кокки под микроскопом. При окрашивании по методу Грамма стафилококк станет синего цвета.
Культуральный метод предполагает выполнение посева исследуемого материала в питательной среде.
Также применяется антибиотикограмма. Данный метод позволяет определить чувствительность данного вида патогенной микрофлоры к антимикробным препаратам. Для этого производится посев патогенной микрофлоры на твердую питательную среду.
Антибиотикограмма необходима для правильного назначения лечения.
Медикаментозное лечение
Золотой стафилококк устойчив ко многим антибиотикам, поэтому лечение усложняется. Важно пройти полный курс антибиотикотерапии. При не завершении лечения антибиотиками в организме незначительное количество бактерий остается, в результате вырабатывается устойчивость к принимаемому препарату.
Для устранения золотистого стафилококка применяют различные антибактериальные препараты. Из группы синтетических пенициллинов: Амоксициллин, Клоксациллин, Цефазолин, Цефалексин, Оксациллин и др.
При гнойном поражении кожи местно применяется Мупироцин. Кожный покров можно обработать зеленкой, перекисью водорода или антибактериальными мазями.
В тяжелых случаях при наличии абсцессов и флегмон проводят хирургическое вскрытие гнойников.
Антистафилококковый бактериофаг, плазма или иммуноглобулин назначают в запущенных случаях.
При заболеваниях ЛОР-органов эффективно помогает Хлорофиллипт. Этот препарат выпускается в виде масляного или спиртового раствора, который используется для полоскания горла.
При стафилококковой токсикоинфекции антибактериальные препараты не назначают. В этом случае больному промывают желудок и внутривенно вводят солевые растворы.
У маленьких детей лечением золотистого стафилококка занимается врач-инфекционист. Ребенка госпитализируют в больницу.
Продолжительность лечения зависит от тяжести заболевания и составляет в среднем 7 дней. В некоторых случаях лечение может длиться несколько месяцев.
Дозировка препаратов строго назначается врачом. Самостоятельное лечение антибиотиками категорически запрещается.
Народное лечение
Успешно применяются в борьбе с золотистым стафилококком народные методы лечения. Существует большое количество лекарственных растений, которые губительно воздействуют на бактерию.
Для борьбы со стафилококковой инфекцией помогают ягоды черной смородины. В них содержится большое количество витаминов и фитонцидов, которые справляются со стафилококком. Ягоды не только помогают укрепить иммунитет, но и усиливают действие некоторых антибиотиков.
Отвар череды – это хорошее средство в борьбе со стафилококком у детей. Взять 250 г сухого сырья и залить литром холодной воды. Емкость поместить на огонь и довести до кипения. Затем прокипятить еще в течение 15-20 минут. После этого оставить на 30 минут настоять. Приготовленный отвар следует добавлять в ванночку при купании малыша.
Избавиться от стафилококка поможет клюквенно-медовая смесь. Взять свежие ягоды и мел в пропорции 2:1 и хорошо перемешать. Затем поставить на час в холодильник. Полученную смесь разделить на несколько порций и употреблять в течение дня.
Отличными помощниками в борьбе со стафилококковой инфекцией являются корень петрушки и сельдерей (2:1). Их следует хорошо вымыть и пропустить через мясорубку. Затем из полученной консистенции выжимают сок. Его необходимо употреблять ежедневно натощак.
При фурункулезе, вызванном стафилококком, поможет чеснок. Взять несколько зубчиков, измельчить и залить водой. Настаивать рекомендуется на протяжении 2 часов. После этого смочить ватный тампон в чесночной воде и прикладывать к пораженному месту.
Кожные поражения золотистым стафилококком лечат с помощью яблочного уксуса. Его добавляют в ванну или делают компрессы. В горячую ванну влить 50 мл уксуса, а для компресса развести 2 столовые ложки в стакане воды.
Если синусит, тонзиллит или гайморит вызван золотистым стафилококком, то для полоскания ротовой полости можно использовать спиртовую настойку прополиса. Для приготовления настойки необходимо взять пару небольших кусочков прополиса, измельчить и залить спиртом. Емкость хранить в темном месте. Прополис оказывает сильное антибактериальное действие.
При использовании народных методов лечения необходимо проконсультироваться с врачом для исключения возможных осложнений.
Последствия золотистого стафилококка
При эндокардите поражается митральный или аортальный клапан. У больного наблюдается повышение температуры тела, увеличивается число сердечных сокращений, снижается работоспособность, возникает боль в суставах и т.д.
Для менингита характерно воспаление мозговых оболочек. Бактерия попадает в головной мозг при пневмонии, синусите или эндокардите. В результате появляются менингеальные симптомы, тремор конечностей, нарушается сознание, появляются судороги.
Синдром токсического шока трудно поддается лечению. Для него характерны следующие симптомы: частая рвота, высокая температура тела, диарея. Развивается синдром из-за выработки стафилококком определенного токсина.
Бактерия может проникнуть в кровь. Сепсис, вызванный золотистым стафилококком, является одним из самых опасных осложнений. Данная форма сепсиса встречается довольно часто. При стафилококковом сепсисе поражаются кишечник, печень, оболочка головного мозга. Это может привести к летальному исходу, если вовремя не предпринимать соответствующих мер.
Чтобы не допустить развитие осложнений, следует при первых симптомах обратиться к врачу. Только правильное и своевременное лечение поможет устранить стафилококковую инфекцию.
Меры профилактики
Чтобы избежать заражения золотистым стафилококком, необходимо соблюдать следующие правила и рекомендации:
- Следует рационально и сбалансировано питаться. При необходимости восполнить витаминную недостаточность.
- Избегать травм. Таким образом удастся свести к минимуму проникновение бактерии внутрь. В случае травмы необходимо обработать поврежденный участок зеленкой и другим антисептическим средством.
- Важно соблюдать санитарно-гигиенические требования. Тщательно и регулярно мыть руки с мылом, проводить влажную уборку в доме и т.д.
Рекомендуется раз в год обследоваться на наличие стафилококка.
Во время просмотра видео Вы узнаете о симптомах золотистого стафилоккока.
Стафилококк (Staphylococcus) – это бактерия, которая имеет правильную шарообразную форму и относится к группе грамположительных неподвижных кокков. Чаще всего под микроскопом можно увидеть скопление таких бактерий, которые по внешнему виду напоминают гроздь винограда.
Благодаря высокой резистентности микроба к антибактериальным препаратам, заболевания стафилококковой этиологии занимают ведущее место среди всей гнойно-воспалительной патологии. Каждому важно знать о стафилококке: что это за болезнь у взрослых, ее симптомы и лечение, чтобы предотвратить необратимые последствия для здоровья.
Стафилококк: что это?
Стафилококк — это неподвижная бактерия шарообразной формы, принадлежащая к семейству Стафилококковые (Staphylococcaceae). Это обширная группа бактерий, насчитывающая 27 видов, 14 из которых обнаруживаются на коже и слизистых человека. При этом лишь 3 вида способны вызывать болезни , поэтому относятся к условно-патогенной микрофлоре. При благоприятных условиях она активно размножается, вызывая различные гнойные процессы в организме человека.
Учитывая тот факт, что стафилококковые инфекции крайне устойчивы к применяемой в их адрес терапии с использованием антибиотиков, в числе гнойно-воспалительных заболеваний стафилококк, симптомы которого могут указывать на воспалительный процесс в любом органе, занимает первое место.
Стафилококк хорошо переносит высокую температуру , а также высушивание. Данные бактерии погибают при температуре 70 – 80ºС в течение 20 – 30 мин, а при температуре 150ºС – практически мгновенно.
Самая распространенная токсическая стафилококковая болезнь — пищевое отравление. Почти 50% всех золотистых стафилококков выделяют энтеротоксин — яд, вызывающий сильнейший понос, рвоту, боли в животе.
Стафилококки прекрасно размножаются во многих пищевых продуктах, особенно любят масляные кремы, овощные и мясные салаты, консервы. В процессе размножения в пище накапливается токсин, и именно с токсином, а не с самим микробом, связаны симптомы заболевания у неосторожного едока.
Все виды этого микроорганизма причисляются к условно-патогенной микрофлоре. Это значит, что здоровому человеку они не грозят, но при неблагоприятных условиях могут стать причиной заболевания.
Существуют три вида стафилококка, которые наиболее распространены и вредоносны для человеческого организма:
- Сапрофитный стафилококк чаще всего поражает женщин, вызывая у них воспалительные заболевания мочевого пузыря (цистит) и почек. Бактерии сапрофитного стафилококка локализуются в слоях кожи гениталий и слизистой оболочке мочеиспускательного канала. Из всех видов стафилококка он вызывает наименьшие поражения;
- Эпидермальный стафилококк . Наиболее опасен у недоношенных, ослабленных детей и у пациентов с иммунодефицитами, онкологическими заболеваниями. Ореолом обитания этого вредителя является слизистая оболочка и кожные покровы.
- Золотистый стафилококк . Это самый опасный вид микроба, который особенно распространен в окружающей среде. Инфицированию подвержены организмы всех возрастных категорий.
Каждый из видов стафилококка имеет множество штаммов (разновидностей), отличающихся друг от друга степенью агрессивности и патогенности
Причины стафилококковой инфекции
Причиной развития практически всех стафилококковых болезней является нарушение целостности кожи или слизистых оболочек, а также употребление зараженных продуктов питания. Уровень вреда также зависит от штамма бактерии, а также функционирования иммунной системы. Чем иммунитет крепче, тем меньше вреда стафилококки способны нанести здоровью человека.
В качестве источника распространения данной инфекции может выступать как больной человек, так и носитель инфекции (бессимптомный), причем такими носителями по определенным данным является порядка более 40% людей , совершенно здоровых. Выступать они могут в качестве носителей любого штамма стафилококка.
Таким образом, можно сделать заключение, что в большинстве случаев, для заболевания стафилококком необходимо сочетание 2х факторов:
- попадание инфекции внутрь;
- нарушение нормального функционирования иммунной системы.
Особенно важными факторами в развитии инфекций являются:
- понижение иммунитета,
- применение сильных медикаментов, иммунодепрессантов,
- хронические патологии,
- проблемы щитовидной железы,
- стрессы, влияние экологии.
Особенно тяжело протекают стафилококковые инфекции у детей раннего возраста и у пожилых людей.
Заболевания вызываемые стафилококками
Золотистый стафилококк способен поражать большинство тканей организма человека. Всего существуют более сотни заболеваний, причиной которых является стафилококковая инфекция. Для стафилококковой инфекции характерно наличие множества различных механизмов, путей и факторов передачи.
Стафилококк у взрослых может стать причиной таких заболеваний:
- Поражения кожи и слизистых – фурункулы, карбункулы, гнойные раны.
- Пищевое отравление.
- Воспаление легких бактериального характера.
- Бронхит.
- Эндокардит.
- Остеомиелит.
- Менингит.
- Заражение крови.
Особенно опасен в этом плане золотистый стафилококк, который может проникнуть в любую точку организма, вызвать генерализованную инфекцию.
Кто предрасположен к инфекции
- Беременные женщины, которым можно сделать иммунизацию анатоксином в32-36 недель.
- К инфекции предрасположены и люди пожилого возраста, особенно имеющие такие заболевания как: ревматизм, сахарный диабет, экзема, онкологические заболевания.
- Любые люди, как взрослые, так и дети, иммунитет которых снижен.
- Медицинские работники, работники общественного питания, в силу своей профессии.
В активную фазу размножения инфекция переходит в моменты:
- переохлаждения организма;
- при протекании ОРЗ и ОРВИ;
- при сбоях эндокринной системы;
- при воспалительных заболеваниях внутренних органов и систем.
Как передается стафилококк человеку?
Все болезни, которые вызывает бактерия, могут возникать в результате того, что инфекция попадает в организм благодаря нарушению целостности кожных покровов или слизистых оболочек, ведь она является постоянным обитателем микрофлоры человека. Кроме того, инфицирование может произойти экзогенным путем, то есть с продуктами питания или в результате тесного контакта.
Основные пути передачи возбудителя:
- Воздушно-капельный . Механизм передачи основан на вдыхании воздуха, в котором содержатся микроорганизмы. Данный механизм передачи становится возможным в случае выделения бактерий в окружающую среду вместе с выдыхаемым воздухом (при заболевании органов дыхательного аппарата: бронхит или пневмония).
- Медицинские инструменты . При отсутствии правил асептики заразиться можно в той же районной поликлинике при плановом осмотре у терапевта.
- Контактно-бытовой : при непосредственном контакте с больным человеком или обсемененными предметами обихода.
- Пищевой – инфицирование возможно при употреблении заражённых продуктов в пищу.
- Фекально-оральный . Напрямую связан с несоблюдением норм гигиены. Стафилококк присутствует в кале и рвотных массах зараженного человека. Передается через грязные руки, с плохо вымытыми овощами, ягодами и фруктами, плохо помытой посуде.
Попадая в организм, стафилококк начинает интенсивно размножаться и вырабатывать токсины, которые негативно сказываются на здоровье, приводя к тем или иным патологиям.
Заражение стафилококком обеспечено, если состояние иммунной системы ослаблено, а человек контактировал с носителем этого микроба.
Симптомы стафилококка
Клиническая картина (симптомы) стафилококка могут быть весьма разнообразными, что зависит от поражаемого органа, штамма бактерии, возраста человека, функциональности (здоровья) иммунитета потенциального больного.
Объединяют все стафилококковые инфекции такие признаки:
- Повышение температуры, локальное (в месте заражения) или общий жар.
- Наличие гнойных процессов.
- Интоксикация – общее ухудшение состояния, потеря аппетита, сонливость, боли в суставах.
Также характерны такие симптомы:
- Гнойники на коже разных размеров: фурункулы, пиодермия, абсцессы и прочее.
- Кашель и ринит с гнойными желтовато-зелеными выделениями.
- Слизь в кале, расстройство стула, тошнота.
- Боли в месте заражения. Например, при стафилококковом остеомиелите начинают болеть кости, эндокардит может сопровождаться сердечными болями.
Стафилококк может поражать практически все системы, ткани и органы, давая клинику стафилококковых локальных или общих заболеваний. Может поражаться кожа, подкожная клетчатка, нервная система, почки, печень, легкие, мочевая система, костная ткань и возникать общее заражение организма (сепсис).
Важно! После заболевания иммунитет к этим микроорганизмам нестойкий. За жизнь можно несколько раз заразиться этими инфекциями. Специальных мер по иммунизации людей от этого вида бактерий нет.
Осложнения
Если человек знает, что такое стафилококк, ему также известно, насколько опасна активная фаза этого патогенного микроорганизма.
- Обострение имеющихся хронических заболеваний дыхательной системы, пищеварительного тракта, сахарного диабета, ревматоидного артрита.
- Попадание в организм других патогенных микробов (стрептококков, пневмококков и др.).
- Развитие септицемии (заражения крови).
Стафилококковая инфекция приводит не только к ряду серьезных заболеваний, но также может осложняться угрожающими жизни состояниями. Патогенный стафилококк, попадая в кровяное русло, способен проникать в сердце, в головной мозг, а в некоторых случаях распространяться во многие органы, вызывая при этом сепсис.
Диагностика
Если есть подозрение на стафилококк – что это, объяснит и диагностирует лечащий врач. Постановка диагноза осуществляется после проведения культурального исследования образцов возбудителя, взятых из очагов инфекции (любых участков нагноения, пузырей, подсохших корок и проч.).
Методы диагностики зависят от того, какой отдел поражен инфекцией.
- Когда речь идет о пневмонии, вызванной стафилококковой инфекцией, достаточно собрать мокроту после откашливания.
- Если инфицирована мочеполовая система, придется собирать анализ мочи.
- При поверхностном поражении – соскобы с кожи и забор со слизистых.
Для диагностики назначают:
- биохимическое исследование крови;
- исследование кала и мочи;
- мазок слюны;
- мазок с кожного покрова.
В ходе проведения анализов также важно выявить, насколько чувствительна бактерия к воздействию антибиотиков, за счет чего возможным станет определение наиболее эффективного препарата для последующего лечения.
Лечение стафилококка у взрослых
Локальные формы стафилококковой инфекции лечат в домашних условиях. Госпитализация показана в случаях генерализации процесса при сепсисе, менингите, эндокардите или при необходимости оперативного лечения гнойно-некротических поражений кожи — фурункулов или карбункулов.
Современный подход к лечению стафилококковых инфекций предусматривает следующие направления лечения:
- Применение современных антимикробных препаратов и антибиотиков;
- Хирургические методы лечения;
- Иммуномодуляционные методы;
- Нормализация гормонального статуса и процесса обмена веществ организма при помощи пищевых добавок (хитозан, кордицепс), минеральных препаратов, витаминов.
Антибиотики
Бактериоскопический посев определяет наличие патогенной флоры и ее вид. Только после этого назначают антибиотические средства в таблетках и уколах, способные убить вредоносную флору.
Однозначно нельзя сказать, какой антибиотик убивает стафилококк, потому что каждый штамм бактерии чувствителен к определенному препарату. К самым часто используемым препаратам относятся следующие группы антибиотиков:
- пенициллиновые;
- целофаспориновые;
- макролиды;
- линкозамиды.
Лечение стафилококковой инфекции требует строгого соблюдения кратности приема, времени употребления лекарственного средства и его дозировки. Важно принимать назначенный антибиотик не до момента исчезновения первых симптомов, а не менее 5 дней . Если необходимо продлить курс, то об этом сообщит доктор. Кроме того, нельзя прекращать лечение, терапия должна быть непрерывной.
Хирургические методы
Цель хирургии при стафилококковой инфекции — вскрытие гнойника и обеспечение хорошего оттока гнойно-воспалительного экссудата. Вскрытые гнойники промываются растворами антибиотиков и дренируются. Широко применяются протеазы — ферменты, которые способны расщеплять пептидные связи в белках и продуктах из распада, тем самым ускоряя очищение гнойных ран.
Бактериофаги при стафилококковой инфекции
Для борьбы со стафилококком могут использоваться бактериофаги – вирусы с избирательной способностью к поражению стафилококка. Для наружного лечения применяют мази, содержащие антибактериальные компоненты, обладающие антисептическим и восстанавливающим действием.
При гнойных процессах не рекомендуется использовать мази, имеющие жировую основу (например, популярный линимент Вишневского) так как жиры препятствуют оттоку отделяемого из раны, тем самым ухудшая течение процесса.
Иммуномодуляторы
Для стимуляции иммунитета у детей и взрослых показано применение препаратов растительного происхождения — эхинацеи (Иммунал), женьшеня (Настойка женьшеня, препараты в виде таблеток и капсул) и Лимонника китайского.
Использование витаминно-минеральных препаратов
Одной из причин снижения иммунитета и частого рецидива инфекций (в том числе и инфекции Золотистого стафилококка) является недостаток в организме витаминов и минералов. Поэтому витаминно-минеральные препараты успешно применяются в лечении и профилактике этих инфекций.
Наиболее оправдано применение этих препаратов при наличии других признаков нехватки витаминов или в период межсезонья.
Перед началом применения витаминных препаратов или пищевых добавок рекомендуем посоветоваться с лечащим врачом и обсудить целесообразность такого лечения, а также связанные с ним риски и последствия.
Как лечить народными средствами
Перед применением любых народных средств от стафилококка, рекомендуем проконсультироваться с врачом.
- Абрикос . При воспалительных процессах на коже из-за стафилококковой инфекции хорошо зарекомендовала себя мякоть абрикоса, которую нужно прикладывать к очагам воспаления. Для лечения внутренней инфекции нужно кушать пюре из абрикосов 2 раза в день – утром и вечером, натощак.
- Кожные стафилококковые инфекции также хорошо лечатся с помощью чеснока . 50 г чеснока измельчается и толчется и перемешивается со 150 мл воды. После процеживания в получившемся настое смачивают бинт и прикладывают к больным местам на коже. Рекомендуется проводить процедуру дважды в день в течение 10 дней.
- Сухой зверобой . Стаканом кипятка заварить 2 ч.л. травы, накрыть тряпкой и дать настояться 30 минут. Принимать на голодный желудок перед завтраком и ужином.
- Рекомендуется к использованию и отвар ромашки . 2 ч.л. ромашки кипятят в стакане воды около пяти минут. Затем отвар процеживается и остужается. Его используют как средство для полоскания, промывания и протирания.
- Хорошим методом лечения стафилококка, является черная смородина . Черная смородина содержит наибольшее количество витамина С, который укрепляет иммунитет и способствует скорейшему выздоровлению. Так же черная смородина будет эффективна при лечении стрептококка.
Категорически запрещено использовать любые тепловые процедуры в домашних условиях для ускорения процессов созревания гнойников. Горячие ванны, баня и сауна только ухудшат состояние больного и приведут к дальнейшему распространению инфекции.
Профилактика
Понимая, как трудно лечить стафилококк, большинство врачей обращают внимание на профилактику развития инфекции. Полностью избавиться от разных видов этого микроорганизма просто невозможно. Поэтому ключевой задачей является не устранение бактерии, а предотвращение развития инфекционного процесса.
Важно проводить регулярную профилактику заболевания, не дожидаясь появления инфекции. В качестве профилактических, используют следующие методы:
- соблюдение гигиены;
- профилактику авитаминоза;
- обработку ранок и порезов антибактериальными средствами;
- предупреждение травм;
- предупреждение потливости;
- тщательная обработка овощей и фруктов перед приемом в пищу,
- исключение из рациона продуктов с нарушенной целостностью упаковки.
Стафилококковые инфекции чрезвычайно опасны для здоровья людей, потому как они способны вызвать серьёзные осложнения. Проводить лечение инфекций этого вида надо под наблюдением специалиста.
Полностью избавится от присутствия стафилококков в организме невозможно. Они являются частью условно-патогенной микрофлоры человека. Малые их количества не наносят никакого вреда.